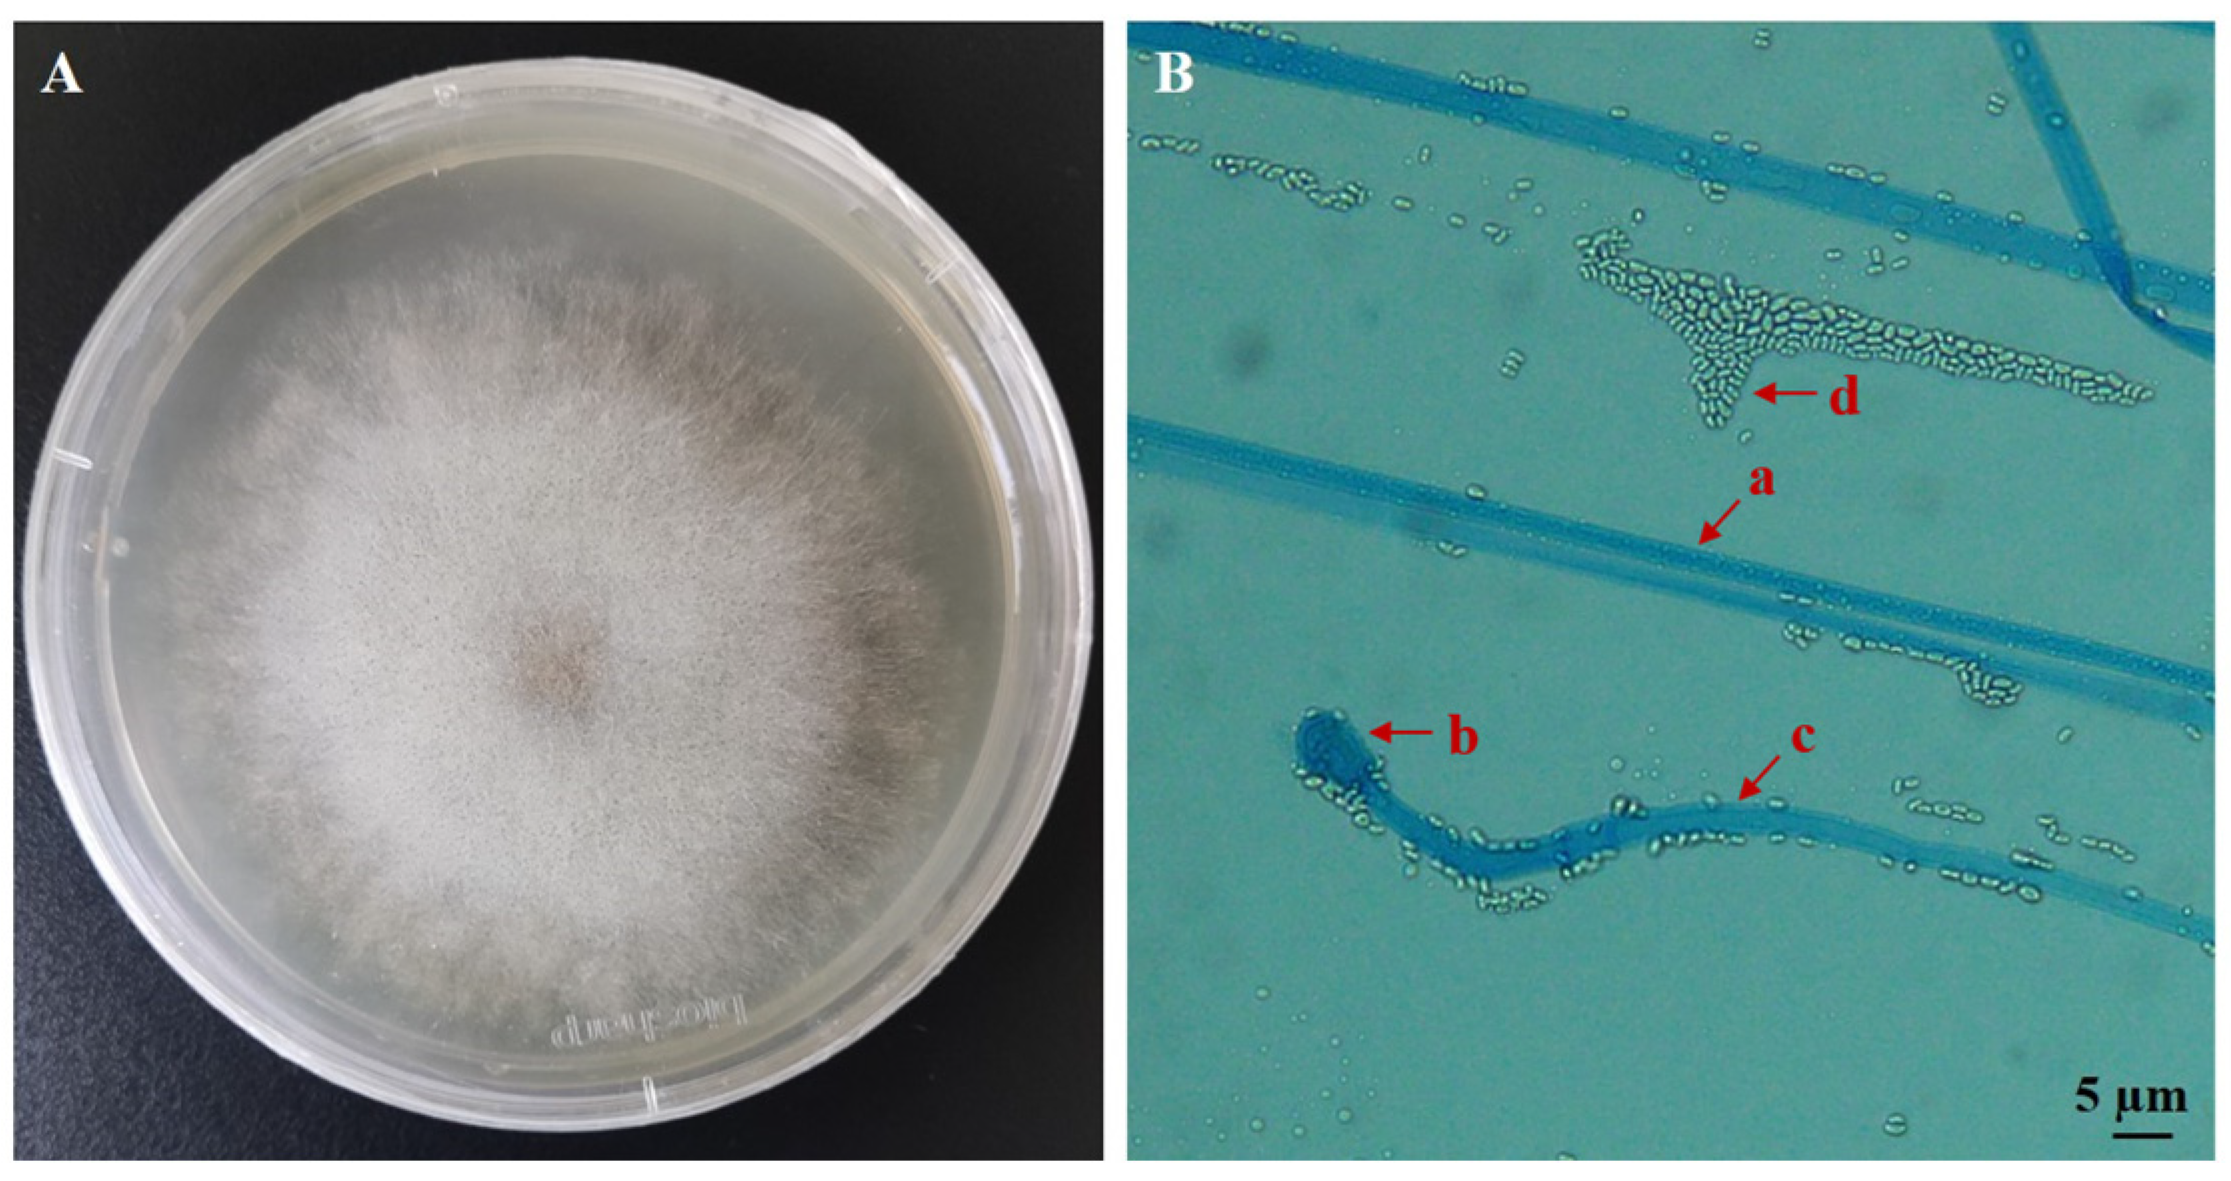
Biology 14 00467 g001

Isolation, Identification, Biological Characterization, and Pathogenicity of Entomopathogenic Fungus from the Larvae of the Evergestis extimalis (Scopoli) (Lepidoptera: Pyralidae)
Simple Summary
Abstract
1. Introduction
2. Materials and Methods
2.1. Isolation of Entomopathogenic Fungus
2.2. Morphological Characterization and Molecular Identification of the Isolated Fungus
2.3. Optimization of the Culture Conditions of the Isolated Fungus
2.3.1. Influence of Medium on Fungal Growth and Sporulation
2.3.2. Optimizing the Carbon and Nitrogen Sources for Fungal Growth and Sporulation
2.3.3. Optimization of Temperature for Fungal Growth and Sporulation
2.3.4. Effect of pH on Fungal Growth and Sporulation
2.3.5. Optimization of Photoperiod for Fungal Growth and Sporulation
2.3.6. Effect of Ultraviolet (UV) Irradiation on Fungal Growth and Sporulation
2.4. Pathogenicity of EPF
2.4.1. Rearing of Insects and EPF Treatment
2.4.2. Bioassay Test
2.4.3. Greenhouse Pot Experiment
2.5. Data Analysis
3. Results
3.1. Identification of the EPF Strain
3.2. Culture Condition Optimization of M. hiemalis
3.3. E. extimalis Larvae Infestation with M. hiemalis QH01
3.4. Pathogenicity of M. hiemalis QH01 Against E. extimalis Larvae
3.5. Greenhouse Experiments
4. Discussion
5. Conclusions
Supplementary Materials
Author Contributions
Funding
Institutional Review Board Statement
Informed Consent Statement
Data Availability Statement
Acknowledgments
Conflicts of Interest
References
- Shao, H.N.; Liu, Y.X.; Liu, Y.J.; Lai, Y.P. The Effect of Ice-Nucleation-Active Bacteria on Metabolic Regulation in Evergestis extimalis (Scopoli) (Lepidoptera: Pyralidae) Overwintering Larvae on the Qinghai-Tibet Plateau. Insects 2022, 13, 909. [Google Scholar] [CrossRef] [PubMed]
- Lai, Y.P.; Tao, K.; Hou, T.P. Preliminary analysis of geographical distribution based on cold hardiness for Evergestis extimalis (Scopoli) (Lepidoptera: Pyralidae) on Qinghai-Tibet Plateau. Entomol. Res. 2019, 49, 13–20. [Google Scholar] [CrossRef]
- Shah, P.A.; Pell, J.K. Entomopathogenic fungi as biological control agents. Appl. Microbiol. Biotechnol. 2003, 61, 413–423. [Google Scholar] [CrossRef] [PubMed]
- Samuels, R.I.; Coracini, D.; Martins dos Santos, C.A.; Gava, C.A.T. Infection of Blissus antillus (Hemiptera: Lygaeidae) eggs by the entomopathogenic fungi Metarhizium anisopliae and Beauveria bassiana. Biol. Control 2002, 23, 269–273. [Google Scholar] [CrossRef]
- Yao, H.Q.; Xie, Y.P.; Wang, E.H. Morphologic observation of Apocheima cinerarius Erschoff (Lepidoptera: Geometridae) pupae and comparison of virulence of Beauveria bassiana infected on them. J. Environ. Entomol. 2015, 37, 348–354. [Google Scholar]
- Cruz-Avalos, A.M.; Bivián-Hernández, M.L.Á.; Ibarra, J.E.; Del Rincón-Castro, M. High virulence of mexican entomopathogenic fungi against fall armyworm, (Lepidoptera: Noctuidae). J. Econ. Entomol. 2019, 112, 99–107. [Google Scholar] [CrossRef]
- Shehzad, M.; Tariq, M.; Mukhtar, T.; Gulzar, A. On the virulence of the entomopathogenic fungi, Beauveria bassiana and Metarhizium anisopliae (Ascomycota: Hypocreales), against the diamondback moth, Plutella xylostella (L.) (Lepidoptera: Plutellidae). Egypt. J. Biol. Pest Control 2021, 31, 86–92. [Google Scholar] [CrossRef]
- Xie, N.; Yin, Y.P.; Zhang, J.W.; Shen, J.F.; Wang, Z.K. Characterization of the Metarhizium anisopliae CQMa128 and its virulence measurements against Lepidoptera insects. In Proceedings of the 2009 Annual Meeting of the Mycological Society of China, Beijing, China, 23–25 August 2009. [Google Scholar]
- Varela, A.; Morales, E. Characterization of some Beauveria bassiana isolates and their virulence toward the Coffee Berry Borer, Hypothenemus hampei. J. Invertebr. Pathol. 1996, 67, 147–152. [Google Scholar] [CrossRef]
- Wraight, S.P.; Inglis, G.D.; Goettel, M.S. Fungi. In Field Manual of Techniques in Invertebrate Pathology: Application and Evaluation of Pathogens for Control of Insects and other Invertebrate Pests; Springer: Dordrecht, The Netherlands, 2007; pp. 223–248. [Google Scholar]
- Steinkraus, D.C. Factors affecting transmission of fungal pathogens of aphids. J. Invertebr. Pathol. 2006, 92, 125–131. [Google Scholar] [CrossRef]
- Alali, S.; Mereghetti, V.; Faoro, F.; Bocchi, S.; Al Azmeh, F.; Montagna, M. Thermotolerant isolates of Beauveria bassiana as potential control agent of insect pest in subtropical climates. PLoS ONE 2019, 14, e0211457. [Google Scholar] [CrossRef]
- Jaronski, S.T. Ecological factors in the inundative use of fungal entomopathogens. BioControl 2010, 55, 159–185. [Google Scholar] [CrossRef]
- Mann, A.J.; Davis, T.S. Plant secondary metabolites and low temperature are the major limiting factors for Beauveria bassiana (Bals.–Criv.) Vuill. (Ascomycota: Hypocreales) growth and virulence in a bark beetle system. BioControl 2020, 141, 104–130. [Google Scholar] [CrossRef]
- Lyu, M.L.; Liu, Z.; Song, Z.; Wang, Y.N.; Liu, X.Y. Diversity and distribution of culturable Mucoromycota fungi in the Greater Khinggan Mountains. J. Biodivers. Sci. 2019, 27, 821–832. [Google Scholar]
- Morrissey, C.O.; Kim, H.Y.; Garnham, K.; Dao, A.; Chakrabarti, A.; Perfect, J.R.; Alastruey-Izquierdo, A.; Harrison, T.S.; Bongomin, F.; Galas, M.; et al. Mucorales: A systematic review to inform the World Health Organization priority list of fungal pathogens. Med. Mycol. 2024, 62, myad130. [Google Scholar] [CrossRef]
- Nentwig, W.; Prillinger, H. A zygomycetous fungus as a mortality factor in a laboratory stock of spiders. J. Arachnol. 1990, 18, 118–121. [Google Scholar]
- Heitor, F. Wound parasitism by the fungus Mucor hiemalis Wehmer in insects. Ann. Epiphyt. 1962, 13, 179–203. [Google Scholar]
- Reiss, J. Biotoxic activity in the Mucorales. Mycopathologia 1993, 121, 123–127. [Google Scholar] [CrossRef]
- Konstantopoulou, M.A.; Mazomenos, B.E. Evaluation of Beauveria bassiana and B. brongniartii strains and four wildtype fungal species against adults of Bactrocera oleae and Ceratitis capitata. BioControl 2005, 50, 293–305. [Google Scholar] [CrossRef]
- Konstantopoulou, M.A.; Milonas, P.; Mazomenos, B.E. Partial purification and insecticidal activity of toxic metabolites secreted by a Mucor hiemalis strain (SMU-21) against adults of Bactrocera oleae and Ceratitis capitata (Diptera: Tephritidae). J. Econ. Entomol. 2006, 99, 1657–1664. [Google Scholar] [CrossRef]
- Hallouti, A.; Ait Hamza, M.; Zahidi, A.; Ait Hammou, R.; Bouharroud, R.; Ait Ben Aoumar, A.; Boubaker, H. Diversity of entomopathogenic fungi associated with Mediterranean fruit fly (Ceratitis capitata (Diptera: Tephritidae)) in Moroccan Argan forests and nearby area: Impact of soil factors on their distribution. BMC Ecol. 2020, 20, 64. [Google Scholar] [CrossRef]
- Wei, J.C. Fungi Identification Manual; Shanghai Scientific & Technical Publishers: Shanghai, China, 1979; pp. 70–74. [Google Scholar]
- Kumar, S.; Nei, M.; Dudley, J.; Tamura, K. MEGA: A biologist-centric software for evolutionary analysis of DNA and protein sequences. Brief. Bioinform. 2008, 9, 299–306. [Google Scholar] [CrossRef] [PubMed]
- Fargues, J.F.; Robert, P.H. Effect of passaging through scarabeid hosts on the virulence and host specificity of two strains of the entomopathogenic hyphomycete Metarhizium anisopliae. Can. J. Microbiol. 1983, 29, 576–583. [Google Scholar] [CrossRef]
- Banu, J.G.; Rajalakshmi, S. Standardisation of media for mass multiplication of entomopathogenic fungi. Indian J. Plant Prot. 2014, 42, 91–93. [Google Scholar]
- Moore, D.; Douro-Kpindou, O.K.; Jenkins, N.E.; Lomer, C.J. Effects of moisture content and temperature on storage of Metarhizium flavoviride conidia. Biocontrol Sci. Technol. 1996, 6, 51–61. [Google Scholar] [CrossRef]
- Huang, P.; Yao, J.A.; Yu, D.Y. Biological Characteristics of Metarhizium anisopliae FM−03 and Its Infection against Planococcus citri. Chin. J. Biol. Control 2018, 34, 858–865. [Google Scholar]
- Hou, Y.; Xia, Y.F.; Xu, J.Q. Identification and Biological Characteristics of a Metarhizium Strain and Its Virulence against Oriental Migratory Locust. Chin. J. Biol. Control 2015, 31, 333–339. [Google Scholar]
- Anwar, A.U.; Xia, S.; Meng, L.; Fahim, R.M.; Zhang, Z.Y.; Zhang, H.Y. Isolation, characterization, culturing, and formulation of a new Beauveria bassiana fungus against Diaphorina citri. BioControl 2021, 158, 104586. [Google Scholar]
- Zhu, G.D.; Ding, W.J.; Xue, M.; Li, Z.; Li, M.; Zhao, Y. Identification and Pathogenicity of a New Entomopathogenic Fungus, Mucor hiemalis (Mucorales: Mucorales), on the Root Maggot, Bradysia odoriphaga (Diptera: Sciaridae). J. Insect Sci. 2022, 22, 2. [Google Scholar] [CrossRef]
- St leger, R.; Nelson, J.O.; Screen, S.E. The entomopathogenic fungus Metarhizium anisopliae alters ambient pH, allowing extracellular protease production and activity. Microbiology 1999, 145, 2691–2699. [Google Scholar] [CrossRef]
- Mishra, S.; Kumar, P.; Malik, A. Effect of temperature and humidity on pathogenicity of native Beauveria bassiana isolate against Musca domestica L. J. Parasit. Dis. 2015, 39, 697–704. [Google Scholar] [CrossRef]
- Cheng, G.H.; Shu, J.; Ding, K.J. Study on Nutrition Demand and Culture Condition of Beauveria bassiana. Chin. Agric. Sci. Bull. 2006, 22, 365–368. [Google Scholar]
- Wang, B.; Fan, M.Z.; Li, Z.Z. Sieving of Selective Media for Beauveria bassiana. J. Anhui Agric. Univ. 2000, 27, 23–28. [Google Scholar]
- Yao, S.L.; Ying, S.H.; Feng, M.G.; Hatting, J.L. In vitro and in vivo responses of fungal biocontrol agents to gradient doses of UV-B and UV-A irradiation. BioControl 2010, 55, 413–422. [Google Scholar] [CrossRef]
- Wang, L.Y.; Sun, Q.; Lin, Z.W.; Wang, H.Z.; Wu, Q.S.; Xin, H.P.; Zhong, X.Z. Occurrence and control of Evergestis extimalis. Chin. Bull. Entomol. 1998, 35, 331–332. [Google Scholar]
- Strak, J.D.; Sherman, M. Toxicity, penetration, and metabolism of acephate in three fruit fly species (Diptera: Tephritidae). J. Econ. Entomol. 1989, 82, 1564–1571. [Google Scholar] [CrossRef]
- Tozlu, E.; Tozlu, G.; Kotan, R. Biocontrol of Cymbalophora rivularis (Menetries) (Lepidoptera: Erebidae) larvae by entomopathogenic bacteria and fungi. Egypt. J. Biol. Pest Control 2022, 32, 66. [Google Scholar] [CrossRef]
- Zhu, G.D.; Ding, W.J.; QIU, J.Y.; Wang, Y.; Xue, M.; Zhao, H.P.; Zhang, G.F. Pathogenicity and field control efficiency of Mucor hiemalis BO-1 against Bradysia odoriphaga Larvae. Chin. J. Biol. Control. 2024, 40, 52–60. [Google Scholar]
- Latifian, M.; Soleimannejadian, E.; Ghazavi, M.; Mosadegh, M.S.; Hayati, J. Effects of sublethal concentrations of fungus Beauveria bassiana on the reproductive potentials of sawtoothed beetle Oryzaephilus surinamensis on commercial date cultivars. Plant Prot. J. 2010, 227–290. [Google Scholar]
- Wang, Y. Poisoning Activity of a New Strain of Mucor hiemalis to Bradysia odoriphaga Yang et Zhang. Master’s Thesis, Shandong Agricultural University, Taian, China, 2021. [Google Scholar]
- Beris, E.; Papachristos, D.; Ponchon, M.; Caca, D.; Kontodimas, D.; Reineke, A. The effects of temperature on pathogenicity of entomopathogenic fungi for controlling larval populations of the European grapevine moth (Lobesia botrana) (Lepidoptera: Tortricidae). J. Crop Prot. 2024, 177, 106542. [Google Scholar] [CrossRef]
- Amatuzzi, R.F.; Poitevin, C.G.; Poltronieri, A.S.; Zawadneak, M.A.C.; Pimentel, I.C. Susceptibility of Duponchelia fovealis Zeller (Lepidoptera: Crambidae) to Soil-Borne Entomopathogenic Fungi. Insects 2018, 9, 70. [Google Scholar] [CrossRef]
- Xie, C.H. Study on Occurrence and Control Countermeasures of Harmful Organisms with Rapeseed in Huangzhong County of Qinghai. Master’s Thesis, Lanzhou University, Lanzhou, China, 2019. [Google Scholar]
- Liu, H.; Skinner, M.; Parker, B.L. Bioassay method for assessing the virulence of Beauveria bassiana against tarnished plant bug, Lygus lineolaris (Hem., Miridae). J. J Appl Entomol. 2003, 127, 299–304. [Google Scholar] [CrossRef]

| Days | Developmental Stage | Virulence Regression Equation | LC50 (Spores/mL) | 95% CI (Spores/mL) |
|---|---|---|---|---|
| 3 | 1st | Y = 0.229X − 1.650 | 1.63 × 107 | 3.21 × 106–6.85 × 108 |
| 2nd | Y = 0.262X − 1.982 | 3.57 × 107 | 8.00 × 106–1.30 × 109 | |
| 3rd | Y = 0.253X − 1.917 | 3.88 × 107 | 8.16 × 106–2.11 × 109 | |
| 4th | Y = 0.238X − 2.259 | 3.13 × 109 | 1.63 × 108–3.89 × 1015 | |
| 5th | Y = 0.241X − 2.362 | 6.53 × 109 | 2.59 × 108–5.93 × 1016 | |
| 4 | 1st | Y = 0.233X − 1.340 | 5.71 × 105 | 1.14 × 104–2.82 × 106 |
| 2nd | Y = 0.312X − 1.918 | 1.40 × 106 | 2.69 × 105–4.73 × 106 | |
| 3rd | Y = 0.275X − 1.720 | 1.83 × 106 | 2.89 × 105–7.72 × 106 | |
| 4th | Y = 0.312X − 2.499 | 1.01 × 108 | 2.27 × 107–3.40 × 109 | |
| 5th | Y = 0.288X − 2.387 | 1.93 × 108 | 3.38 × 107–2.33 × 1010 | |
| 5 | 1st | Y = 0.289X − 1.412 | 7.77 × 104 | 1.07 × 103–4.00 × 105 |
| 2nd | Y = 0.294X − 1.528 | 1.58 × 105 | 5.15 × 103–6.83 × 105 | |
| 3rd | Y = 0.267X − 1.525 | 5.23 × 105 | 2.92 × 104–2.14 × 106 | |
| 4th | Y = 0.344X − 2.397 | 9.13 × 106 | 3.05 × 106–4.22 × 107 | |
| 5th | Y = 0.326X − 2.355 | 1.69 × 107 | 5.24 × 106–1.21 × 108 |
| Concentration (Spores/mL) | Developmental Stage | Virulence Regression Equation | LT50 (Days) | 95% CI (Days) |
|---|---|---|---|---|
| 1 × 105 | 1st | Y = 0.265X − 1.365 | 5.15 | 4.38–12.86 |
| 2nd | Y = 0.300X − 1.612 | 5.38 | 4.61–10.39 | |
| 3rd | Y = 0.296X − 1.564 | 5.29 | 4.54–10.20 | |
| 4th | # | # | # | |
| 5th | # | # | # | |
| 1 × 106 | 1st | Y = 0.347X − 1.186 | 3.41 | 2.00–3.95 |
| 2nd | Y = 0.363X − 1.481 | 4.08 | 3.46–4.80 | |
| 3rd | Y = 0.298X − 1.262 | 4.24 | 3.51–5.63 | |
| 4th | # | # | # | |
| 5th | # | # | # | |
| 1 × 107 | 1st | Y = 0.353X − 1.148 | 3.25 | 1.63–3.80 |
| 2nd | Y = 0.299X − 1.068 | 3.57 | 1.71–4.21 | |
| 3rd | Y = 0.275X − 1.072 | 3.90 | 2.46–4.90 | |
| 4th | # | # | # | |
| 5th | # | # | # | |
| 1 × 108 | 1st | Y = 0.421X − 1.261 | 2.99 | 1.60–3.51 |
| 2nd | Y = 0.391X − 1.176 | 3.01 | 1.39–3.55 | |
| 3rd | Y = 0.373X − 1.258 | 3.37 | 2.12–3.88 | |
| 4th | Y = 0.385X − 1.557 | 4.04 | 3.45–4.66 | |
| 5th | Y = 0.367X − 1.614 | 4.40 | 3.88–5.40 |
Disclaimer/Publisher’s Note: The statements, opinions and data contained in all publications are solely those of the individual author(s) and contributor(s) and not of MDPI and/or the editor(s). MDPI and/or the editor(s) disclaim responsibility for any injury to people or property resulting from any ideas, methods, instructions or products referred to in the content. |
© 2025 by the authors. Licensee MDPI, Basel, Switzerland. This article is an open access article distributed under the terms and conditions of the Creative Commons Attribution (CC BY) license (https://creativecommons.org/licenses/by/4.0/).
Share and Cite
Ma, Y.; Qin, M.; Zeng, Y.; Shen, Y.; Lai, Y.; Lu, G. Isolation, Identification, Biological Characterization, and Pathogenicity of Entomopathogenic Fungus from the Larvae of the Evergestis extimalis (Scopoli) (Lepidoptera: Pyralidae). Biology 2025, 14, 467. https://doi.org/10.3390/biology14050467
Ma Y, Qin M, Zeng Y, Shen Y, Lai Y, Lu G. Isolation, Identification, Biological Characterization, and Pathogenicity of Entomopathogenic Fungus from the Larvae of the Evergestis extimalis (Scopoli) (Lepidoptera: Pyralidae). Biology. 2025; 14(5):467. https://doi.org/10.3390/biology14050467
Chicago/Turabian StyleMa, Youhua, Minggang Qin, Yuanfang Zeng, Yinyin Shen, Youpeng Lai, and Guangxin Lu. 2025. "Isolation, Identification, Biological Characterization, and Pathogenicity of Entomopathogenic Fungus from the Larvae of the Evergestis extimalis (Scopoli) (Lepidoptera: Pyralidae)" Biology 14, no. 5: 467. https://doi.org/10.3390/biology14050467
APA StyleMa, Y., Qin, M., Zeng, Y., Shen, Y., Lai, Y., & Lu, G. (2025). Isolation, Identification, Biological Characterization, and Pathogenicity of Entomopathogenic Fungus from the Larvae of the Evergestis extimalis (Scopoli) (Lepidoptera: Pyralidae). Biology, 14(5), 467. https://doi.org/10.3390/biology14050467





